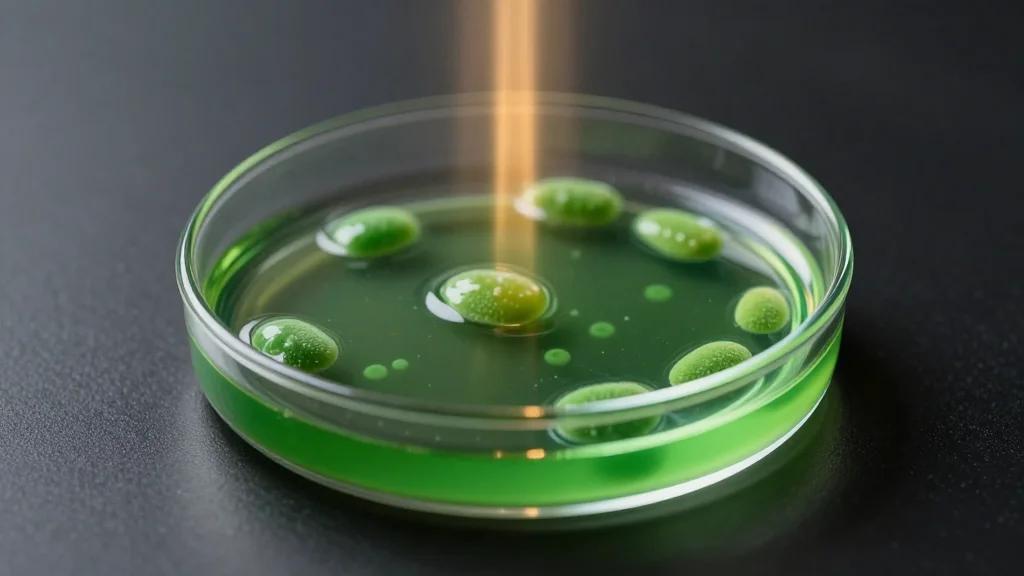
Schrodinger Inc (SDGR) Q4 2025 Earnings Call Transcript

Motley Fool – Earnings Transcripts
Full earnings call transcripts from The Motley Fool

Ironwood Pharmaceuticals Inc (IRWD) Q4 2025 Earnings Call Transcript
IQVIA reported fourth‑quarter 2025 revenue of $4.34 billion, a 10.3% year‑over‑year increase, driven by strong organic growth and roughly two percentage points from recent acquisitions. Adjusted EBITDA rose 5% to $1.046 billion and adjusted diluted EPS climbed 9.6% to $3.42. The company highlighted its AI‑enabled solutions, the launch of a strategic partnership with Amazon Web Services, and the upcoming 2026 segment realignment into Commercial Solutions and R&D. Guidance for 2026 projects revenue between $17.159 billion and $17.359 billion with adjusted EPS of $12.55‑$12.85.

McGrath RentCorp (MGRC) Q4 2025 Earnings Call Transcript
McGrath RentCorp posted Q4 2025 net income of $34.8 million, or $2.79 per share, and full‑year earnings of $134 million, $10.41 per share. Loan growth accelerated to more than 12% quarter‑over‑quarter while deposits rose 7.4% in the quarter, indicating strong demand. At...

Green Brick Partners Inc (GRBK) Q4 2025 Earnings Call Transcript
Green Brick Partners posted a record 898 net orders in Q3 2025, driving 953 home closings and net income of $78 million, though earnings per share fell 11% to $1.77. Gross margin slipped to 31.1% but stayed above 30%, aided by...

Tri Pointe Homes Inc (Delaware) (TPH) Q4 2025 Earnings Call Transcript
Tri Pointe Homes reported delivering 1,217 homes in the quarter at an average price of $672,000, generating $817 million in sales revenue and a 21.6% adjusted gross margin after $8 million of inventory charges. The company repurchased 1.5 million shares for $51 million, reducing...

OraSure Technologies Inc (OSUR) Q4 2025 Earnings Call Transcript
LivaNova reported Q4 2025 revenue of $361 million, a 9.5% constant‑currency increase, and delivered adjusted EPS of $0.86, marking its fifth straight year of double‑digit earnings growth. The cardiopulmonary segment grew 10% year‑over‑year, propelled by ESSENCE heart‑lung machine placements, while epilepsy...

Seadrill Ltd (SDRL) Q4 2025 Earnings Call Transcript
Seadrill reported Q4 2025 revenue of $176 million and adjusted EBITDA of $109 million, while posting a $4.7 million net loss due to a $23 million charter settlement. The company booked an $11.3 million gain on the sale of a Suezmax tanker, delivering about $26 million...

Newmark Group Inc (NMRK) Q4 2025 Earnings Call Transcript
Newmark Group reported a 25.9% revenue jump to $863.5 million in Q3 2025, with double‑digit growth across all major lines. Capital markets revenue surged 59.7% as debt volumes rose 129% and investment‑sale activity jumped 67%. The company completed the RealFoundations acquisition, launched...

Barrett Business Services Inc (BBSI) Q4 2025 Earnings Call Transcript
Barrett Business Services reported an 8.6% increase in gross billings to $2.32 billion for Q4 2025, driven by strong PEO growth and a record addition of 10,400 worksite employees, up 6.1% year‑over‑year. Net income per diluted share rose 7% to $0.79,...

Arko Corp. (ARKO) Q4 2025 Earnings Call Transcript
Arko Corp reported Q3 2025 adjusted EBITDA of $75.2 million, down year‑over‑year but above the midpoint of its guidance, while net income rose to $13.5 million. The company highlighted progress on its dealerization program, converting 350 stores and targeting over...

GoodRx Holdings Inc (GDRX) Q4 2025 Earnings Call Transcript
GoodRx reported full‑year 2024 revenue of $792.3 million, a 6% year‑over‑year increase, with Q4 revenue of $198.6 million. Adjusted EBITDA rose 20% to $260.2 million, and the adjusted EBITDA margin expanded to 32.8%, up 420 basis points. Prescription‑transaction revenue grew 5% driven by...

Chord Energy Corp (CHRD) Q4 2025 Earnings Call Transcript
Ichor Holdings reported fourth‑quarter 2025 revenue of $223.6 million, slightly down sequentially but above the midpoint of its outlook, and finished the fiscal year with $948 million in revenue, a 12% year‑over‑year increase driven by strong etch and deposition sales. Gross margin...

Urban Outfitters Inc (URBN) Q4 2026 Earnings Call Transcript
Urban Outfitters reported a record third‑quarter revenue of $1.5 billion, up 12% year‑over‑year, and net income of $116 million, a 13% increase. All five brands posted positive comparable sales, with the Urban brand delivering a 13% global comp and Anthropologie achieving its...

Marriott Vacations Worldwide Corp (VAC) Q4 2025 Earnings Call Transcript
Marriott Vacations Worldwide reported strong Q4 2025 results, with adjusted EBITDA up 9% to $1.4 billion and full‑year adjusted EBITDA rising 8% to $5.38 billion. The company expanded its portfolio to nearly 1.78 million rooms across 9,800 properties, adding a record 610,000‑room pipeline...

Ashford Hospitality Trust Inc (AHT) Q4 2025 Earnings Call Transcript
Armada Hoffler Properties announced a rebrand to A H Realty Trust and a strategic exit from its multifamily, construction and fee‑income businesses, refocusing on retail and office assets. Management is near final terms to sell 11 of 14 multifamily properties...

Allot Ltd (ALLT) Q4 2025 Earnings Call Transcript
Gilat Satellite Networks reported a 75% year‑over‑year revenue jump to $137 million in Q4 2025, delivering $451.7 million for the full year, driven by strong commercial, defense, and Peru segments. Adjusted EBITDA rose 50% to $18.2 million in the quarter, while GAAP gross...

ADTRAN Holdings Inc (ADTN) Q4 2025 Earnings Call Transcript
Airgain reported Q4 2025 revenue of $12.1 million, matching the low end of its guidance, while full‑year revenue fell 15% to $51.8 million. Consumer sales rose 20% year‑over‑year, driven by Wi‑Fi 7 antenna shipments, whereas enterprise and automotive segments declined sharply...

Innoviz Technologies Ltd (INVZ) Q4 2025 Earnings Call Transcript
Innoviz Technologies reported record first‑half 2025 revenue of $27.1 million, a 46% YoY increase, and reduced Q2 cash burn to $7.3 million while holding $79.4 million in cash. The company reaffirmed its full‑year revenue target of $50‑$60 million and raised its NRE booking outlook...

Arcus Biosciences Inc (RCUS) Q4 2025 Earnings Call Transcript
ArcBest reported Q4 2025 consolidated revenue of $973 million, a 3% decline year‑over‑year, and non‑GAAP EPS fell to 36 cents. The asset‑based segment posted flat per‑day revenue but modest shipment and tonnage growth, while the asset‑light unit achieved breakeven operating results thanks...

SmartStop Self Storage REIT Inc (STSFF) Q4 2025 Earnings Call Transcript
STAG Industrial reported Q4 2025 core FFO of $0.66 per share and $2.55 for the year, a 6.3% increase YoY, driven by 5.4% same‑store cash NOI growth and record leasing activity. The company added 31 leases covering 3 million square feet,...

Climb Global Solutions Inc (CLMB) Q4 2025 Earnings Call Transcript
Core Laboratories reported Q4 2025 revenue of $138.3 million, up 3% sequentially and 7% year‑over‑year, driven by stronger international demand for reservoir description services. The Reservoir Description segment posted $92.3 million in revenue with a 14% operating margin, while Production Enhancement revenue...

Spok Holdings Inc (SPOK) Q4 2025 Earnings Call Transcript
SPS Commerce reported another year of growth, posting $751.5 million revenue for 2025, up 18% year‑over‑year, and a 13% increase in Q4 to $192.7 million. Recurring revenue rose 20% and adjusted EBITDA grew 24% to $231.4 million, while average revenue per user reached...

Geron Corp (GERN) Q4 2025 Earnings Call Transcript
Geron Corp reported full‑year 2025 Rytelo net revenue of $184 million, with Q4 sales of $48 million, and projected 2026 revenue between $220 million and $240 million. Operating expenses are expected to dip to $230‑$240 million, a $20 million reduction year‑over‑year, while cash balances sit at...

Nutanix Inc (NTNX) Q2 2026 Earnings Call Transcript
Nutanix reported Q1 FY2026 revenue of $671 million, up 13% YoY and within its $670‑$680 million guidance, while ARR grew 18% to $2.284 billion and NRR held at 109%. The company lowered its full‑year revenue outlook to $2.82‑$2.86 billion, citing higher‑than‑expected revenue deferral from...

Skywater Technology Inc (SKYT) Q4 2025 Earnings Call Transcript
SkyWater Technology reported Q4 2024 revenue of $75.5 million with a 26.6% gross margin, beating guidance and delivering a positive EPS of $0.04. Full‑year revenue reached a record $342 million, up 19% year‑over‑year, driven by strong ATS growth and record...

Ellington Financial Inc (EFC) Q4 2025 Earnings Call Transcript
Principal Financial Group delivered a strong full‑year 2025 performance, posting adjusted non‑GAAP EPS growth of 12% and reported EPS growth near 20%, beating its own targets. Operating margins expanded to 31% and ROE rose to 15.7%, the high end of...

National Storage Affiliates Trust (NSA) Q4 2025 Earnings Call Transcript
Insight Enterprises reported Q4 2025 revenue of $2 billion, a 1% decline driven by a 4% drop in product sales and an 18% fall in on‑prem software as customers migrate to cloud. Gross profit rose 9% to a 23.4% margin, marking...

Agilon Health Inc (AGL) Q4 2025 Earnings Call Transcript
Agilon Health reported FY 2025 revenue of $5.93 billion but posted a negative medical margin of $57 million and an adjusted EBITDA loss of $296 million, with the medical cost trend rising to 6.5% and a $35 million operating expense reduction. Management guided 2026 revenue...

Hci Group Inc (HCI) Q4 2025 Earnings Call Transcript
Hercules Capital reported record Q4 2025 performance, originating $1.06 billion in new debt and reaching $4 billion in annual originations while expanding platform AUM to $5.7 billion, a 20.5% increase. Total investment income rose 7.9% year‑over‑year to $532.5 million, and net investment income generated...

TKO Group Holdings Inc (TKO) Q4 2025 Earnings Call Transcript
TKO Group Holdings reported Q3 2025 revenue of $1.12 billion, a 27% decline driven by the loss of On Location Olympic revenue, while adjusted EBITDA surged 59% to $360 million, lifting the margin to 32%. The company secured a seven‑year, $7.7 billion UFC...

Sarepta Therapeutics Inc (SRPT) Q4 2025 Earnings Call Transcript
Sarepta Therapeutics reported a blockbuster fourth quarter, with ELEVIDYS gene‑therapy sales of $384 million, surpassing guidance by $60 million, and total net product revenue of $1.79 billion for 2024, up 56% year‑over‑year. The company achieved GAAP profitability and cash‑flow positivity, confirming the financial...
Schrodinger Inc (SDGR) Q4 2025 Earnings Call Transcript
Schrödinger reported Q2 FY2025 revenue of $54.8 million, up 16% year‑over‑year, driven by 15% software growth to $40.5 million and 19% drug‑discovery growth to $14.2 million. Gross margin slipped to 68% as the mix shifted toward lower‑margin services and new predictive‑toxicology investments. Net...

Array Technologies Inc (ARRY) Q4 2025 Earnings Call Transcript
Array Technologies reported Q3 2025 revenue of $393 million, a 70% year‑over‑year increase, driven by 74% volume growth and strong new‑product adoption. Adjusted gross margin held at 28.1% despite tariff and commodity pressures, while adjusted EBITDA rose 55% to $72 million. The...

StandardAero, Inc. (SARO) Q4 2025 Earnings Call Transcript
StandardAero reported a record $6.05 billion in 2025 revenue, up 15.8% year‑over‑year, driven by double‑digit organic growth across its Engine Services and Component Repair segments. Adjusted EBITDA rose 17% to $888 million and free cash flow surged to $209 million, reflecting stronger pricing,...

Crescent Capital BDC Inc (CCAP) Q4 2025 Earnings Call Transcript
Crescent Capital BDC reported Q4 2025 net investment income of $0.46 per share, delivering 110% coverage of its $0.42 regular dividend. Net asset value slipped to $19.28 per share, driven by $0.15 per share of unrealized losses from tariff‑impacted borrowers....

Nu Holdings Ltd (NU) Q4 2025 Earnings Call Transcript
Nu Skin Enterprises reported FY 2025 adjusted EPS of $1.27, a 51% increase, with full‑year revenue of $1.49 billion and Q4 revenue of $370 million, both within guidance. Operating margin rose to 6.7% and cash balance reached $240 million while debt fell to...

Agilent Technologies Inc (A) Q1 2026 Earnings Call Transcript
Agilent Technologies reported Q1 2026 core revenue of $1.8 billion, up 4.4% year‑over‑year, and non‑GAAP earnings per share of $1.36, meeting internal expectations despite a $10 million hit from a winter storm. Operating margin held at 24.6% after a 50‑basis‑point decline, while...

Revolution Medicines Inc (RVMD) Q4 2025 Earnings Call Transcript
Revolution Medicines reported that its lead KRAS inhibitor doraxonrasib secured breakthrough therapy, orphan drug, and a FDA National Priority Voucher, underscoring its potential in pancreatic cancer. Phase I data revealed median overall survival of 13.1‑15.6 months and a 47% objective...

Procept Biorobotics Corp (PRCT) Q4 2025 Earnings Call Transcript
Procept Biorobotics reported a 48% year‑over‑year revenue increase to $79.2 million in Q2 2025, driven by strong U.S. growth and a 58% surge in handpiece and consumable sales. Gross margin expanded to 65.4%, up 640 basis points, while adjusted EBITDA loss narrowed...

HNI Corp (HNI) Q4 2025 Earnings Call Transcript
HNI Corp reported third‑quarter 2025 non‑GAAP EPS of $1.10, a 7% year‑over‑year increase, and posted a record non‑GAAP operating margin of 10.8%. Workplace furnishings sales rose 3% organically, with segment margin surpassing 12% after a 40‑basis‑point improvement. Management reaffirmed its...

Trade Desk Inc (TTD) Q4 2025 Earnings Call Transcript
Nvidia announced a return to the consumer PC market with new low‑power system‑on‑chip devices slated for Dell, Lenovo and other OEMs. The chips combine CPU and GPU functions, aiming to extend battery life and diversify Nvidia’s revenue beyond data centers....

Soleno Therapeutics Inc (SLNO) Q4 2025 Earnings Call Transcript
Soleno Therapeutics reported $190.4 million in net revenue for fiscal 2025, representing less than nine months of commercial sales of its VICAT XR therapy. The company turned profitable, posting $20.9 million net income and generating $48.7 million of operating cash in Q4, ending the...

Montrose Environmental Group Inc (MEG) Q4 2025 Earnings Call Transcript
Montrose Environmental Group reported first‑quarter 2022 revenue of $134.7 million, a modest 0.6% year‑over‑year increase, driven by strong organic growth in its measurement‑and‑analysis and remediation segments. PFAS water‑treatment and biogas services surged, while COVID‑related CTEH revenues continued to normalize below historic...

Astec Industries Inc (ASTE) Q4 2025 Earnings Call Transcript
Astec Industries reported a strong Q4 2025, with adjusted EBITDA climbing 55.7% year‑over‑year to $27.1 million and net sales up 20.1% thanks to robust demand for asphalt and concrete plants and the TerraSource acquisition. The company’s backlog expanded to $449.5 million, including...

Teladoc Health Inc (TDOC) Q4 2025 Earnings Call Transcript
Teladoc Health reported Q2 2025 revenue of $631.9 million, a modest 1.6% decline YoY, while adjusted EBITDA reached $69.3 million, hitting the high end of guidance. Integrated care drove growth, delivering $391.5 million in revenue and expanding U.S. membership to 102.4 million, surpassing 100 million members....

APi Group Corp (APG) Q4 2025 Earnings Call Transcript
S&P Global reported a strong fourth‑quarter 2025, with revenue up 9% year‑over‑year and organic constant‑currency growth of 8%. Adjusted operating margin expanded 60 basis points to 47.3% and adjusted diluted EPS rose 14%, hitting the top end of its guidance....

Clear Secure Inc (YOU) Q4 2025 Earnings Call Transcript
Clear Secure Inc. posted record Q4 2025 results, with revenue of $240.8 million, a 16.7% year‑over‑year increase, and total bookings up 25.4% to $287.1 million, driven largely by ClearOne enterprise wins. Adjusted EBITDA reached $79.9 million, delivering a 33.2% margin, while free cash...

Mirum Pharmaceuticals Inc (MIRM) Q4 2025 Earnings Call Transcript
Mirum Pharmaceuticals reported $521 million in 2025 net product sales, a 55% year‑over‑year increase driven by Livmarli and bile‑acid medicines, surpassing guidance. Operating expenses rose to $543 million, yet the company generated positive cash flow and ended the year with $391 million in...

BKV Corp (BKV) Q4 2025 Earnings Call Transcript
BKV Corporation announced it will increase its stake in the power joint venture to 75%, securing majority control and greater governance over capital decisions. Management highlighted robust free cash flow that will fund debt reduction, power‑sector investments, and its expanding...

US Physical Therapy Inc (USPH) Q4 2025 Earnings Call Transcript
Sensus Healthcare reported Q4 2025 revenue of $4.9 million, a steep decline from $31 million a year earlier, as sales to its former largest customer evaporated. The company highlighted the launch of exclusive CPT codes for its SRT and IGSRT platforms, which...

Ibotta Inc (IBTA) Q4 2025 Earnings Call Transcript
Ibotta reported Q4 2025 revenue of $83.3 million, a 16% year‑over‑year decline, and non‑GAAP gross margin of 80%, down roughly 800 basis points. The company highlighted strong traction for its LiveLift pilots, with an 83% re‑up rate, and announced a...